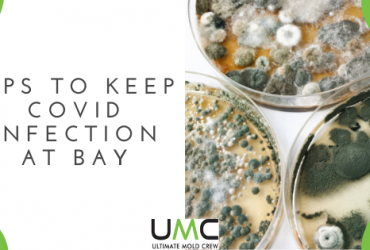
Tips To Keep COVID Infection AT Bay Tips To Keep COVID Infection AT Bay

Sanitization & Disinfection Cleaning Mississauga
⭐Eco-Friednly Sanitizing & Disinfection Services In Mississauga
Do you need a professional coronavirus cleaning service in Mississauga or nearby location? To stop the flow of coronavirus in Canada, we are here with our 24×7 emergency service for coronavirus sanitization and disinfection.
⭐Get Virus Disinfection & Sanitization by Experts
UMC- Ultimate Mold Crew is the leading company for the remediation of biohazard diseases and infectious viruses including the coronavirus.
We have the highest standard of sanitization and cleaning. Our experienced team of officials use hi-technology equipment to clean off the virus and perform bacterial cleaning to help stop the flow of virus in your home or commercial spaces.
Areas We Serve – Coronavirus Cleaning Toronto – Coronavirus Cleaning Brampton
We have the best cleaning and sanitizing service in Mississauga. The sanitization process for coronavirus required to decontaminate your environment is a very detailed one. Get your office or home decontaminated with our service. We ensure your safety.
While combating any disease or virus especially the coronavirus, registered products are required to get the job done in the correct manner. We take your family’s health seriously. So, we take all the necessary precautions which are essential to protect you from covid-19.
We perform bacterial surface cleaning to stop the spread of this virus in your home or any commercial area. So get your home or work places decontaminated as soon as possible.
Taking preventive measures are essential in today’s time in order to keep your family safe and healthy.
GET RID OF CORONAVIRUS AT YOUR HOME/OFFICE IN MiSSISSAUGA -.CALL US TODAY 647-985-2739
Mississauga Disinfection Sanitization and Cleaning Services
As of now, coronavirus is declared as a global pandemic. In recent times there has been a constant increase in the cases of Covid-19 in Mississauga. So disinfecting services are also in demand. The cleaning of this virus can also be done at home. But there is a requirement of certain equipment and expertise to deal with this deadly virus. So, the job is best done if left to be done by the professionals. UMC has the best trained and experienced team of officials for the cleaning service.
COVID-19
Get the latest information from Health Canada on COVID-19.
See more resources on Google
Disinfection Cleaning At Home & Office
While making a choice for cleaning and disinfecting service, here are some things which you should take care of:
- The most important thing to be considered is that the products used for cleaning and sanitization must be registered.
- It should satisfy HIPA standards without risking the life of people with any odour or risk of degradation of equipment.
Our agents have a secure individual protection to ensure safety for them and for you as well. They are well trained in the disinfection method and handling of equipment.
Here are some of the measures which you can take on your behalf to avoid the spread of coronavirus at your home.
- Practise regular cleaning of frequently touched surfaces such as door knobs, tables, switches, handles etc.
- Use a sanitizer of proper dilution.
- Take necessary precautions while cleaning such as wearing gloves and do ensure that the area to be cleaned must have a proper air supply as some products can be highly acidic in nature.
Our company has the best expertise and equipment for cleaning and disinfecting.
Choosing A Cleaning Company in Mississauga
Here are some of the things which you should look at while choosing the best cleaning and disinfecting service during this pandemic.
The most important thing to look for is that the product used for cleaning must be approved by the health sector.
It should meet HIPA standard without the risk of people or any odor or risk of degradation of equipment.
If you provide us a chance we will ensure your safety. Our agents have individual protection to provide a secure service to you. They are trained in handling all the equipment and disinfection methods.
Ultimate mold crew is one amongst the best cleaning service providers in Canada. Now, we are expanding our service in Mississauga as well. We are trying our best to control the spread of coronavirus in Canada. We strictly adhere to government guidelines in terms of safety measures. We have our own guidelines too, to protect our employees at work to ensure your safety as well.
In such a crucial time of a global pandemic, it is our goal to provide the best cleaning service in Canada. So,
Our 3 Step Cleaning Process
Cleaning Process
This process is required to remove dirt, germs and other bacterial impurities from a surface. Any water soap mixture or detergent can be used for this process. But it doesn’t remove germs 100%. Cleaning only reduces the spread of infection and anybody coming in contact with the infected surface.
At first the area to be disinfected is evacuated. As the virus has now become air borne so in the beginning the space is ozonated to purify the air. Then all the surfaces present in that area are cleaned in depth to ensure the removal of germs and all the other impurities.
Open spaces are also disinfected as they can become the region where the virus can persist for days.
Disinfection Process
Disinfecting helps to kill the germs present on any surface or object.
It lowers the risk of spread of infection as certain chemicals are used to kill the germs. Some examples of the products which can be used are bleach, chlorine wipes, disinfecting spray or hand sanitizer.
Sanitization Process
The process of cleaning ends here as sanitization is the last step. All the surfaces and corners must be sanitized properly. The sanitization is done close to the floor and surfaces to avoid the generation of aerosols.
Spraying sanitizer with the help of a gun or any specified spraying machine treats a large area within a short period of time. So, the person in charge of sanitization uses technical methods to spray the sanitizer.
Why You Should Hire Our Cleaning Experts?
This service will be performed frequently if your employees are present at your premises. In residential areas, where there is a covid patient nearby or in your home, you can avail our emergency coronavirus cleaning services.
The Ultimate Mold Crew is one of the best cleaning service providers in Ontario province. We follow proper government guidelines and help to stop the flow of Coronavirus.
We are now offering our decontamination services in mississauga. We have guidelines and rules to protect our employees at work in order to ensure your safety.
In the time of crisis the goal of our business is to provide our best service and help to prevent the spread of this Pandemic in Canada.
We are prepared for every situation in advance. If required then we can serve our customers with maximum efficiency. We are 100% operational and if you need our help then we will get back to you as soon as possible.
In residential areas if there is a covid case in, or, nearby your home, then you can make use of our emergency coronavirus cleaning services in mississauga, Ontario, Canada.
Our goal is to provide you a safe and healthy environment for your family and loved ones.